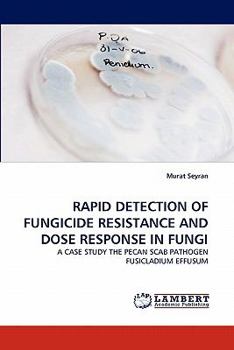
Paperback Rapid Detection of Fungicide Resistance and Dose Response in Fungi Book

Rapid Detection of Fungicide Resistance and Dose Response in Fungi
Fungicide resistance in fungal plant pathogens causes failure of plant disease control, loss of grower confidence to fungicides, yield losses and environmental pollution. The Pecan scab disease caused... This description may be from another edition of this product.
Format:Paperback
Language:English
ISBN:3844314849
ISBN13:9783844314847
Release Date:March 2011
Publisher:LAP Lambert Academic Publishing
Length:100 Pages
Weight:0.35 lbs.
Dimensions:0.2" x 6.0" x 9.0"
Customer Reviews
0 rating